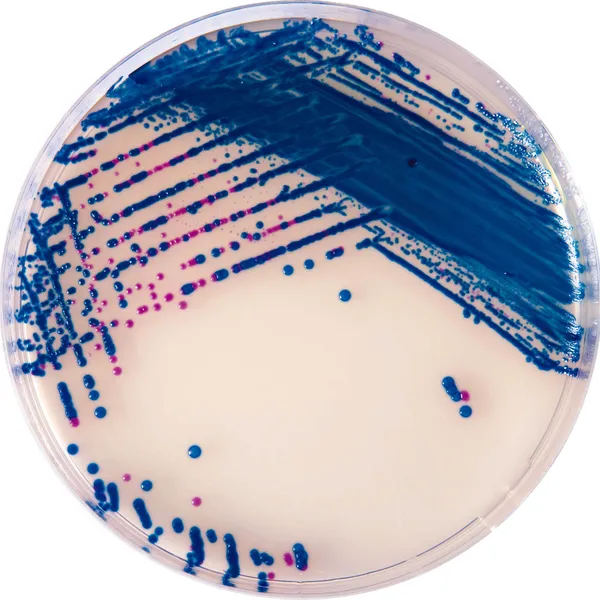
CHROMagar™ StrepB

Hình thái khuẩn lạc

Streptococcus nhóm B
Màu tím nhạt

Vi sinh vật khác
Màu xanh, không màu hoặc bị ức chế
Hiệu năng
Hiệu năng
GBS ở phụ nữ mang thai: Nhóm B Streptococci (GBS), còn được biết đến dưới tên Streptococcus agalactiae, là nguyên nhân gây ra nhiều nhiễm khuẩn ở người lớn nhưng phần lớn là nguyên nhân quan trọng gây nhiễm khuẩn nghiêm trọng ở trẻ sơ sinh, xảy ra trong ba tuần đầu của cuộc đời. Các nghiên cứu chỉ ra rằng khoảng 12-27 % phụ nữ mang thai bị mang GBS. (WHO, Bệnh truyền nhiễm, Nhóm B Streptococcus). Phát hiện tình trạng mang khuẩn GBS ở âm đạo (và ở một số quốc gia cũng làm trên trực tràng) ở phụ nữ mang thai là chiến lược hiệu quả nhất để ngăn ngừa sự lây truyền nhiễm trùng khi sinh con.
Trên toàn thế giới, các hướng dẫn chính thức khuyến nghị tầm soát GBS trước khi sinh trong tháng cuối của thai kỳ. Đối với những phụ nữ mang GBS, việc tầm soát này cho phép xác định sự cần thiết của việc dùng kháng sinh dự phòng trong khi chuyển dạ, điều này đã được chứng minh là hiệu quả trong việc ngăn ngừa nhiễm trùng xảy ra trong tuần đầu đời (gọi là nhiễm GBS khởi phát sớm).
Mục đích sử dụng:
CHROMagar™ StrepB là một môi trường nuôi cấy chromogen chọn lọc được thiết kế để hỗ trợ trong việc xác định định tính tình trạng mang Streptococcus nhóm B (GBS) ở phụ nữ mang thai. Môi trường này hỗ trợ sự phát triển của các chủng GBS gây tiêu huyết và không gây tiêu huyết. Bài kiểm tra được thực hiện bằng cách cấy trực tiếp, hoặc sau khi làm giàu, các mẫu nước tiểu, gạc âm đạo và/hoặc gạc âm đạo/trực tràng lấy từ phụ nữ mang thai. Kết quả CHROMagar™ StrepB có thể được diễn giải sau khi ủ hiếu khí 18-24 giờ ở 35-37 °C.
CHROMagar™ StrepB không nhằm chẩn đoán nhiễm trùng cũng như hướng dẫn hoặc theo dõi điều trị nhiễm trùng. Cần thực hiện thêm xác định, thử nghiệm độ nhạy và phân loại dịch tễ học trên các khuẩn lạc nghi ngờ.
1. Dễ diễn giải: Dễ đọc hơn nhờ màu sắc khuẩn lạc có màu tím đậm rõ ràng.
2. Độ nhạy cao : Sự phát hiện GBS, bao gồm cả các chủng không tiêu huyết, với độ nhạy gần 100 %.
5. Đơn giản : Ủ trong điều kiện hiếu khí. Không cần CO2. Xác nhận bằng ngưng kết latex có thể được thực hiện trực tiếp từ khuẩn lạc.
3. Độ đặc hiệu cao: Phân biệt GBS với các vi khuẩn khác bằng cách ức chế chọn lọc hoặc thông qua sự đổi màu đối kháng.
 <img src="/Data-EN-5-1754045201.png" width="1024" height="515" alt="" title="Data EN" />
<img src="/Data-EN-5-1754045201.png" width="1024" height="515" alt="" title="Data EN" /> Thành phần
 <img class="vce-single-image" src="/Composition-EN-1-1754045203.png" width="720" height="480" alt="" title="Composition EN" />
<img class="vce-single-image" src="/Composition-EN-1-1754045203.png" width="720" height="480" alt="" title="Composition EN" /> Tài liệu kỹ thuật
Công bố khoa học
2023
Utilidad del CHROMagarTMStrepBpara la detección de Streptococcus agalactiaeen hisopado vaginorrectalde gestantes
? Publication2023
Group B Streptococci Colonization in Pregnant Guatemalan Women: Prevalence, Risk Factors, and Vaginal Microbiome
? Publication2023
Fluctuation of Group B Streptococcus colonization rates in pregnant women according to COVID-19 pandemic-related events in Brazil
? Publication2022
Group B Streptococcus colonization among pregnant women before and after the onset of the COVID-19 pandemic in Brazil
? Publication2019
Identification of Group B Streptococcus on Chromogenic Medium CHROMagar StrepB by MALDI-ToF Mass Spectrometry
? Publication2016
Evaluation of conventional and CHROMagar methods for the detection of Group B Streptococcus in antenatal cases
? Publication2015
Group B Streptococcus (GBS). Bacteruria in Prengancy. Comparison of four culture media
? Publication2015
Evaluation of four chromogenic media for the isolation of Group B Streptococcus from vaginal specimens in pregnant women
? Publication2014
CHROMagar Strep B and Granada Media for detection of group B Streptococcus in vaginal/rectal prenatal screening
? Publication2014
Comparison of culture-based methods for Group B Streptococcus detection in screening samples from pregnant women
? Publication2013
Evaluation of Trans-Vag Broth, Colistin-Nalidixic Agar and CHROMagar StrepB for Detection of Group B Streptococcus in Vaginal and Rectal Swabs from Pregnant Women in South Africa
? Publication2012
Comparison of CHROMagar StrepB, Columbia CNA agar and Lim broth for the isolation of Group B Streptococcus from vaginal and rectal swabs from South Africa
? Publication2012
Prepartum vaginal/anorectal Group B Streptococcus screening: Improvement of the enrichment step by the broth additive RambaQUICK StrepB
? Publication2011
Evaluation of CHROMagar™ StrepB agar, an aerobic chromogenic medium for prepartum vaginal/rectal Group B Streptococcus screening
? Publication2010
Détection rapide par culture de Streptococcus agalactiae dans les prélevements génitaux sur un nouveau milieu chromogène: CHROMagar StrepB
? Publication2010
Rapid Detection with culture media of Streptococcus agalactiae in genital samples on a new chromogenic media CHROMagar StrepB
? Publication2010
Comparison of the Rate of Recovery of Group B Streptococci from Genital Specimens Inoculated into Group B Selective Broth and Sub-cultured to Neomycin Nalidixic Acid Plates and Three Different Chromogenic Media
? Publication2010
Group B Streptococcus Detection by Carrot Broth/CHROMagar Colorex GBS Agar vs. Conventional Colistin/Nalidixic Acid Agar/Group B Strep Broth Method
? Publication2010
Evaluation of CHROMagar™ StrepB: A new chromogenic agar medium for aerobic detection of Group B Streptococci in perinatal samples
? Publication2010
Perpartum anti Group B Streptococcus Antibioprophylaxis : What would be the impact of the CDC’s Guidelines in a French Hospital ?
? Publication2010
Perpartum antibioprophylaxis : comparison of Group B Streptococcus detection rates of two chromogenic media and blood agar for its isolation in pregnant women vaginal swabs
? Publication

Xem thêm